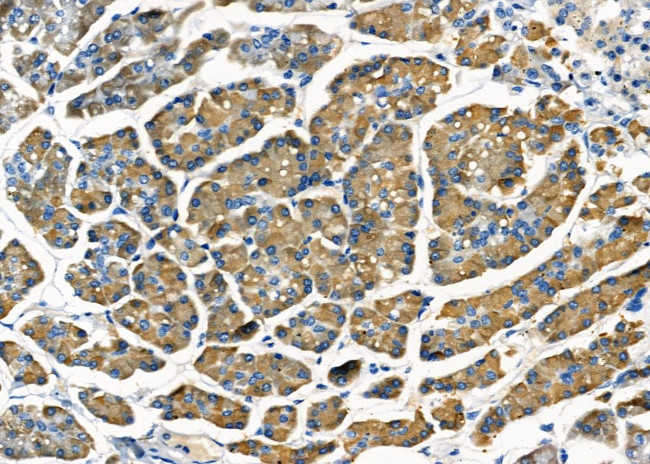
STT3B Antibody in Immunohistochemistry (Paraffin) (IHC (P))

Search
Invitrogen
STT3B Polyclonal Antibody
{{$productOrderCtrl.translations['antibody.pdp.commerceCard.promotion.promotions']}}
{{$productOrderCtrl.translations['antibody.pdp.commerceCard.promotion.viewpromo']}}
{{$productOrderCtrl.translations['antibody.pdp.commerceCard.promotion.promocode']}}: {{promo.promoCode}} {{promo.promoTitle}} {{promo.promoDescription}}. {{$productOrderCtrl.translations['antibody.pdp.commerceCard.promotion.learnmore']}}
图: 1 / 3
STT3B Antibody (PA5-106380) in IHC (P)



Please note: We are reviewing Western blot images included in the antibody testing data in our catalog, including those provided by third parties. Unless expressly labeled or annotated as “raw-unedited”, Western blot images included in the antibody testing data in our catalog may have been edited, optimized or otherwise adjusted for presentation.
产品信息
PA5-106380
种属反应
已发表种属
宿主/亚型
分类
类型
抗原
偶联物
形式
浓度
规格
纯化类型
保存液
内含物
保存条件
运输条件
RRID
产品详细信息
Antibody detects endogenous levels of total STT3B.
靶标信息
Catalytic subunit of the oligosaccharyl transferase (OST) complex that catalyzes the initial transfer of a defined glycan (Glc(3)Man(9)GlcNAc(2) in eukaryotes) from the lipid carrier dolichol-pyrophosphate to an asparagine residue within an Asn-X-Ser/Thr consensus motif in nascent polypeptide chains, the first step in protein N-glycosylation. N-glycosylation occurs cotranslationally and the complex associates with the Sec61 complex at the channel-forming translocon complex that mediates protein translocation across the endoplasmic reticulum (ER). All subunits are required for a maximal enzyme activity. This subunit contains the active site and the acceptor peptide and donor lipid-linked oligosaccharide (LLO) binding pockets. STT3B is present in a small subset of OST complexes and mediates both cotranslational and post-translational N-glycosylation of target proteins: STT3B-containing complexes are required for efficient post-translational glycosylation and while they are less competent than STT3A-containing complexes for cotranslational glycosylation, they have the ability to mediate glycosylation of some nascent sites that are not accessible for STT3A. STT3B-containing complexes also act post-translationally and mediate modification of skipped glycosylation sites in unfolded proteins. Plays a role in ER-associated degradation (ERAD) pathway that mediates ubiquitin-dependent degradation of misfolded endoplasmic reticulum proteins by mediating N-glycosylation of unfolded proteins, which are then recognized by the ERAD pathway and targeted for degradation. Mediates glycosylation of the disease variant AMYL-TTR 'Asp-38' of TTR at 'Asn-118', leading to its degradation.
仅用于科研。不用于诊断过程。未经明确授权不得转售。
生物信息学
蛋白别名: B6dom1 antigen; Dolichyl-diphosphooligosaccharide--protein glycosyltransferase subunit STT3B; Oligosaccharyl transferase subunit STT3B; Source of immunodominant MHC-associated peptides; Source of immunodominant MHC-associated peptides homolog; STT3-B
基因别名: 1300006C19Rik; RGD1311563; SIMP; STT3B
UniProt ID: (Mouse) Q3TDQ1
Entrez Gene ID: (Rat) 363160, (Mouse) 68292